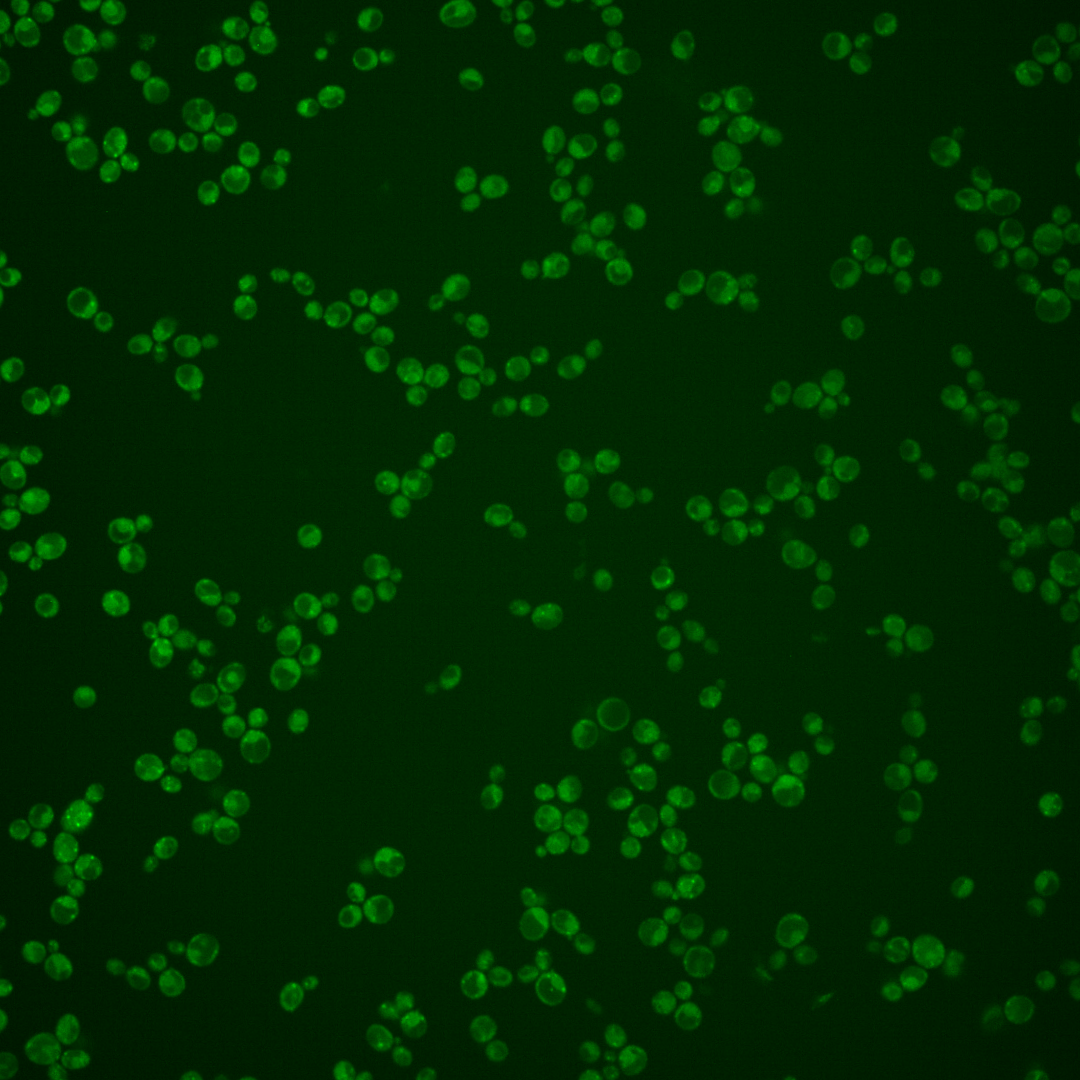
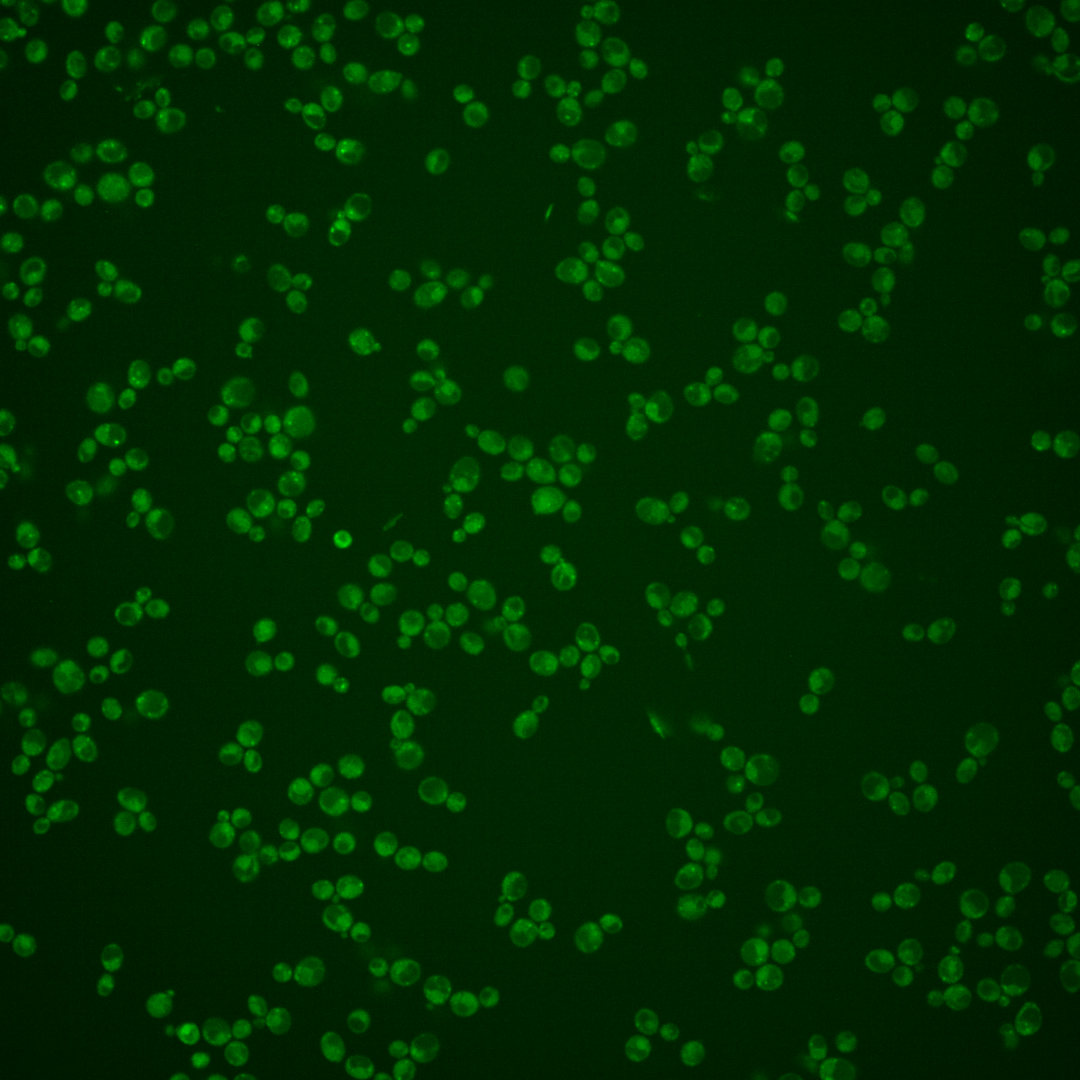
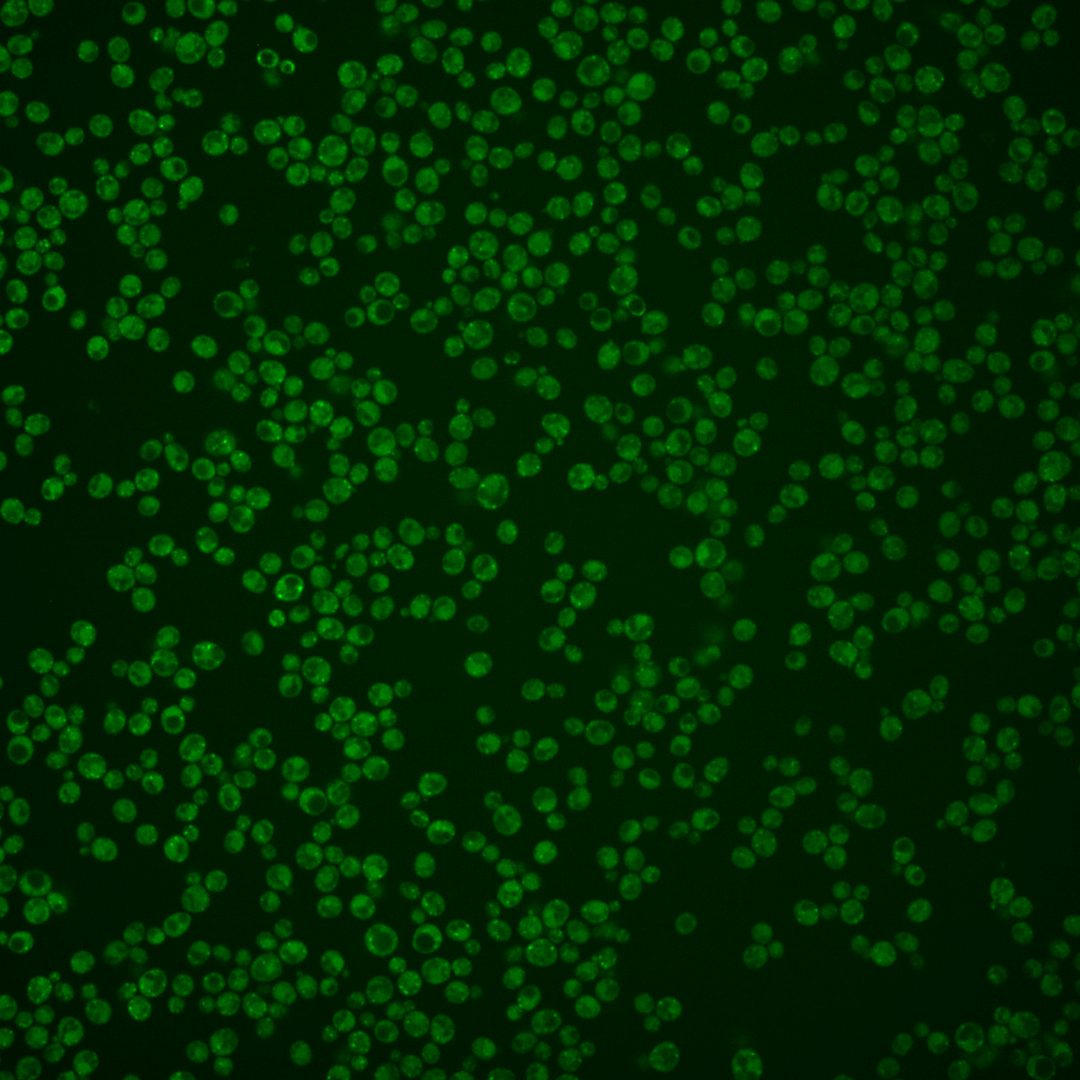

| Standard name | |
|---|---|
| Human Ortholog | |
| Description | Protein involved in retention of membrane proteins; including Sec12p, in the ER; localized to Golgi; functions as a retrieval receptor in returning membrane proteins to the ER |
Micrographs




















































































Sub-cellular Localization
Yeast GFP Assignment
Protein Abundance
Localization Change
External localization resources
| ensLOC | DeepLoc | |||||||||||||||||||||||
|---|---|---|---|---|---|---|---|---|---|---|---|---|---|---|---|---|---|---|---|---|---|---|---|---|
| Localization | WT1 | WT2 | WT3 | RAP60 | RAP140 | RAP220 | RAP300 | RAP380 | RAP460 | RAP540 | RAP620 | RAP700 | HU80 | HU120 | HU160 | rpd3Δ_1 | rpd3Δ_2 | rpd3Δ_3 | WT1 | WT2 | WT3 | AF100 | AF140 | AF180 |
| Cortical Patches | 11 | 24 | 11 | 5 | 4 | 4 | 0 | 2 | 0 | 0 | 0 | 3 | 19 | 15 | 4 | 15 | 10 | 14 | 10 | 33 | 14 | 7 | 12 | 11 |
| Bud | 2 | 0 | 4 | 8 | 8 | 12 | 27 | 29 | 22 | 34 | 28 | 37 | 1 | 2 | 2 | 1 | 3 | 5 | 1 | 2 | 0 | 6 | 3 | 3 |
| Bud Neck | 0 | 0 | 0 | 0 | 0 | 0 | 1 | 0 | 0 | 0 | 0 | 0 | 1 | 1 | 1 | 0 | 0 | 0 | 3 | 3 | 1 | 1 | 0 | 2 |
| Bud Site | 0 | 0 | 0 | 0 | 0 | 0 | 3 | 2 | 5 | 9 | 2 | 5 | 0 | 0 | 0 | 0 | 0 | 0 | – | – | – | – | – | – |
| Cell Periphery | 2 | 0 | 0 | 0 | 1 | 2 | 0 | 2 | 2 | 1 | 1 | 4 | 0 | 1 | 0 | 2 | 0 | 1 | 0 | 0 | 0 | 0 | 0 | 0 |
| Cytoplasm | 44 | 81 | 48 | 113 | 171 | 148 | 236 | 232 | 154 | 282 | 162 | 266 | 57 | 88 | 66 | 76 | 52 | 43 | 11 | 25 | 11 | 8 | 12 | 25 |
| Endoplasmic Reticulum | 32 | 59 | 34 | 23 | 11 | 12 | 11 | 2 | 1 | 3 | 4 | 19 | 34 | 64 | 13 | 5 | 3 | 8 | 27 | 36 | 27 | 11 | 18 | 27 |
| Endosome | 9 | 10 | 13 | 25 | 55 | 8 | 27 | 13 | 4 | 18 | 1 | 0 | 18 | 12 | 34 | 27 | 13 | 26 | 31 | 28 | 29 | 16 | 20 | 16 |
| Golgi | 1 | 5 | 3 | 7 | 0 | 0 | 0 | 0 | 0 | 0 | 0 | 0 | 0 | 9 | 3 | 0 | 1 | 1 | 36 | 42 | 34 | 19 | 17 | 15 |
| Mitochondria | 5 | 0 | 47 | 65 | 79 | 151 | 298 | 289 | 249 | 296 | 244 | 404 | 1 | 1 | 1 | 10 | 3 | 9 | 30 | 27 | 32 | 35 | 50 | 54 |
| Nucleus | 0 | 0 | 0 | 0 | 0 | 0 | 2 | 3 | 1 | 3 | 2 | 4 | 0 | 0 | 0 | 0 | 0 | 0 | 0 | 0 | 1 | 0 | 0 | 0 |
| Nuclear Periphery | 0 | 1 | 0 | 0 | 0 | 1 | 1 | 1 | 1 | 0 | 0 | 0 | 0 | 1 | 0 | 0 | 0 | 0 | 0 | 0 | 0 | 1 | 0 | 0 |
| Nucleolus | 0 | 0 | 0 | 0 | 2 | 0 | 1 | 1 | 1 | 0 | 1 | 0 | 0 | 0 | 1 | 0 | 0 | 0 | 0 | 0 | 0 | 0 | 0 | 0 |
| Peroxisomes | 0 | 0 | 0 | 5 | 5 | 0 | 4 | 4 | 2 | 6 | 0 | 2 | 1 | 0 | 1 | 0 | 0 | 0 | 2 | 1 | 5 | 4 | 2 | 2 |
| SpindlePole | 1 | 0 | 1 | 7 | 6 | 3 | 14 | 15 | 15 | 26 | 4 | 21 | 2 | 2 | 4 | 8 | 3 | 12 | 2 | 1 | 1 | 0 | 1 | 1 |
| Vac/Vac Membrane | 1 | 1 | 0 | 1 | 7 | 0 | 6 | 9 | 4 | 11 | 5 | 5 | 5 | 2 | 11 | 2 | 6 | 8 | 7 | 6 | 2 | 8 | 12 | 15 |
| Unique Cell Count | 96 | 162 | 130 | 226 | 303 | 290 | 508 | 491 | 373 | 551 | 356 | 608 | 123 | 178 | 130 | 127 | 83 | 103 | 167 | 213 | 165 | 123 | 157 | 180 |
| Labelled Cell Count | 108 | 181 | 161 | 259 | 349 | 341 | 631 | 604 | 461 | 689 | 454 | 770 | 139 | 198 | 141 | 146 | 94 | 127 | 167 | 213 | 165 | 123 | 157 | 180 |
Yeast GFP Assignment
Protein Abundance
| Screen | WT1 | WT2 | WT3 | RAP60 | RAP140 | RAP220 | RAP300 | RAP380 | RAP460 | RAP540 | RAP620 | RAP700 | HU80 | HU120 | HU160 | rpd3Δ_1 | rpd3Δ_2 | rpd3Δ_3 | AF100 | AF140 | AF180 |
|---|---|---|---|---|---|---|---|---|---|---|---|---|---|---|---|---|---|---|---|---|---|
| Mean Cell GFP Intensity (1e-4) | 6.4 | 8.1 | 5.6 | 5.0 | 5.3 | 4.3 | 3.9 | 3.8 | 3.4 | 3.5 | 3.2 | 3.3 | 7.2 | 7.2 | 7.2 | 7.3 | 7.8 | 7.3 | 7.9 | 8.0 | 7.3 |
| Std Deviation (1e-4) | 1.0 | 1.6 | 1.2 | 1.3 | 2.0 | 1.2 | 1.3 | 1.2 | 0.9 | 0.9 | 0.8 | 0.7 | 1.5 | 1.4 | 1.3 | 1.2 | 1.4 | 1.3 | 1.8 | 1.8 | 1.4 |
| Intensity Change (Log2) | – | – | – | -0.16 | -0.08 | -0.37 | -0.53 | -0.57 | -0.69 | -0.69 | -0.79 | -0.75 | 0.36 | 0.38 | 0.36 | 0.4 | 0.49 | 0.39 | 0.5 | 0.52 | 0.4 |
Localization Change
| Localization | RAP60 | RAP140 | RAP220 | RAP300 | RAP380 | RAP460 | RAP540 | RAP620 | RAP700 | HU80 | HU120 | HU160 | rpd3Δ_1 | rpd3Δ_2 | rpd3Δ_3 |
|---|---|---|---|---|---|---|---|---|---|---|---|---|---|---|---|
| Cortical Patches | -2.7 | 0 | 0 | 0 | 0 | 0 | 0 | 0 | 0 | 1.7 | 0 | -1.9 | 0.9 | 0.9 | 1.3 |
| Bud | 0 | 0 | 0 | 0 | 0 | 0 | 0 | 0 | 0 | 0 | 0 | 0 | 0 | 0 | 0 |
| Bud Neck | 0 | 0 | 0 | 0 | 0 | 0 | 0 | 0 | 0 | 0 | 0 | 0 | 0 | 0 | 0 |
| Bud Site | 0 | 0 | 0 | 0 | 0 | 0 | 0 | 0 | 0 | 0 | 0 | 0 | 0 | 0 | 0 |
| Cell Periphery | 0 | 0 | 0 | 0 | 0 | 0 | 0 | 0 | 0 | 0 | 0 | 0 | 0 | 0 | 0 |
| Cytoplasm | 2.4 | 3.7 | 2.7 | 2.0 | 2.1 | 0.9 | 2.9 | 1.7 | 1.4 | 1.5 | 2.2 | 2.2 | 3.7 | 3.7 | 0.7 |
| Endoplasmic Reticulum | -4.0 | -7.0 | 0 | 0 | 0 | 0 | 0 | 0 | 0 | 0.3 | 1.8 | -3.4 | -5.0 | -4.2 | -3.6 |
| Endosome | 0.3 | 2.1 | 0 | 0 | 0 | 0 | 0 | 0 | 0 | 1.1 | -1.0 | 3.4 | 2.5 | 1.2 | 3.1 |
| Golgi | 0 | 0 | 0 | 0 | 0 | 0 | 0 | 0 | 0 | 0 | 1.2 | 0 | 0 | 0 | 0 |
| Mitochondria | -1.4 | -2.1 | 0 | 0 | 0 | 0 | 0 | 0 | 0 | -7.2 | -8.5 | -7.4 | -5.5 | -5.5 | -4.9 |
| Nucleus | 0 | 0 | 0 | 0 | 0 | 0 | 0 | 0 | 0 | 0 | 0 | 0 | 0 | 0 | 0 |
| Nuclear Periphery | 0 | 0 | 0 | 0 | 0 | 0 | 0 | 0 | 0 | 0 | 0 | 0 | 0 | 0 | 0 |
| Nucleolus | 0 | 0 | 0 | 0 | 0 | 0 | 0 | 0 | 0 | 0 | 0 | 0 | 0 | 0 | 0 |
| Peroxisomes | 0 | 0 | 0 | 0 | 0 | 0 | 0 | 0 | 0 | 0 | 0 | 0 | 0 | 0 | 0 |
| SpindlePole | 0 | 0 | 0 | 0 | 0 | 0 | 0 | 0 | 0 | 0 | 0 | 0 | 0 | 0 | 3.6 |
| Vacuole | 0 | 0 | 0 | 0 | 0 | 0 | 0 | 0 | 0 | 0 | 0 | 3.4 | 0 | 0 | 0 |
External localization resources
Images






























Protein Concentration and Protein Localization Data
| R1 | R2 | R3 | ||||||||||||||||
|---|---|---|---|---|---|---|---|---|---|---|---|---|---|---|---|---|---|---|
| G1 Pre-START | G1 Post-START | S/G2 | Metaphase | Anaphase | Telophase | G1 Pre-START | G1 Post-START | S/G2 | Metaphase | Anaphase | Telophase | G1 Pre-START | G1 Post-START | S/G2 | Metaphase | Anaphase | Telophase | |
| Concentration | 2.4874 | 3.01 | 3.0138 | 2.3508 | 2.4259 | 2.9063 | 3.3991 | 4.8694 | 4.0284 | 4.1966 | 4.2895 | 3.9486 | 1.2437 | 2.7431 | 2.3331 | 2.1607 | 2.1103 | 1.9772 |
| Actin | 0.0559 | 0.0117 | 0.024 | 0.0387 | 0.0347 | 0.0313 | 0.0613 | 0.0805 | 0.062 | 0.0013 | 0.0342 | 0.0287 | 0.0215 | 0.0059 | 0.0158 | 0.0075 | 0.0043 | 0.0155 |
| Bud | 0.0006 | 0.0008 | 0.0006 | 0.0004 | 0.0006 | 0.0004 | 0.0005 | 0.0004 | 0.0009 | 0.0005 | 0.008 | 0.0005 | 0.0004 | 0.0006 | 0.0005 | 0.0008 | 0.0003 | 0.0015 |
| Bud Neck | 0.0014 | 0.0006 | 0.0009 | 0.0007 | 0.0012 | 0.0047 | 0.0022 | 0.001 | 0.0064 | 0.0001 | 0.0003 | 0.0035 | 0.0029 | 0.0004 | 0.0008 | 0.0005 | 0.0005 | 0.0019 |
| Bud Periphery | 0.0008 | 0.0006 | 0.0005 | 0.0002 | 0.0006 | 0.0008 | 0.0005 | 0.0005 | 0.001 | 0.0001 | 0.0243 | 0.0013 | 0.0006 | 0.0005 | 0.0007 | 0.002 | 0.0003 | 0.0006 |
| Bud Site | 0.0057 | 0.0048 | 0.0056 | 0.0006 | 0.0018 | 0.0009 | 0.0258 | 0.0088 | 0.0035 | 0.0004 | 0.0025 | 0.0006 | 0.0043 | 0.0028 | 0.0027 | 0.0008 | 0.0004 | 0.0005 |
| Cell Periphery | 0.0006 | 0.0004 | 0.0004 | 0.0002 | 0.0003 | 0.0004 | 0.0017 | 0.002 | 0.0002 | 0 | 0.0004 | 0.0003 | 0.0005 | 0.0002 | 0.0004 | 0.0006 | 0.0001 | 0.0002 |
| Cytoplasm | 0.076 | 0.1815 | 0.1279 | 0.0371 | 0.0301 | 0.0558 | 0.0577 | 0.0474 | 0.0589 | 0.0592 | 0.0405 | 0.0855 | 0.0644 | 0.0646 | 0.0512 | 0.0787 | 0.0483 | 0.0747 |
| Cytoplasmic Foci | 0.1725 | 0.2028 | 0.1681 | 0.138 | 0.1759 | 0.1715 | 0.1671 | 0.2525 | 0.202 | 0.1158 | 0.1563 | 0.1677 | 0.1798 | 0.1885 | 0.1727 | 0.153 | 0.1973 | 0.1895 |
| Eisosomes | 0.0003 | 0.0001 | 0.0002 | 0.0002 | 0.0006 | 0.0006 | 0.0005 | 0.0014 | 0.0001 | 0 | 0.0005 | 0.0002 | 0.0003 | 0.0001 | 0.0002 | 0.0001 | 0.0001 | 0.0001 |
| Endoplasmic Reticulum | 0.0262 | 0.0229 | 0.0303 | 0.0099 | 0.0305 | 0.0179 | 0.023 | 0.0083 | 0.0234 | 0.0122 | 0.0202 | 0.0116 | 0.0138 | 0.0099 | 0.0082 | 0.0285 | 0.017 | 0.0093 |
| Endosome | 0.2994 | 0.2836 | 0.309 | 0.4887 | 0.3207 | 0.2988 | 0.2151 | 0.2567 | 0.2819 | 0.3835 | 0.3469 | 0.2365 | 0.3285 | 0.3624 | 0.34 | 0.3564 | 0.2912 | 0.3367 |
| Golgi | 0.2216 | 0.2092 | 0.26 | 0.253 | 0.2908 | 0.3257 | 0.2503 | 0.2352 | 0.2861 | 0.4085 | 0.1801 | 0.3366 | 0.2608 | 0.2805 | 0.3173 | 0.251 | 0.3023 | 0.283 |
| Lipid Particles | 0.0257 | 0.0136 | 0.0097 | 0.0097 | 0.0132 | 0.0178 | 0.0307 | 0.0122 | 0.0154 | 0.0056 | 0.0137 | 0.0295 | 0.0375 | 0.0187 | 0.0187 | 0.0222 | 0.0197 | 0.0167 |
| Mitochondria | 0.0215 | 0.0128 | 0.0222 | 0.0126 | 0.0169 | 0.0188 | 0.0115 | 0.0056 | 0.0097 | 0.0054 | 0.0326 | 0.0216 | 0.0218 | 0.0172 | 0.0291 | 0.0587 | 0.0102 | 0.0193 |
| None | 0.0533 | 0.0303 | 0.0206 | 0.0009 | 0.0521 | 0.0249 | 0.069 | 0.0678 | 0.0133 | 0.0003 | 0.0894 | 0.0292 | 0.0306 | 0.0279 | 0.0134 | 0.007 | 0.0461 | 0.0322 |
| Nuclear Periphery | 0.0027 | 0.0022 | 0.0022 | 0.0006 | 0.0045 | 0.0007 | 0.0052 | 0.0008 | 0.0013 | 0.0008 | 0.0098 | 0.0006 | 0.0015 | 0.0006 | 0.0024 | 0.0063 | 0.0214 | 0.0014 |
| Nucleolus | 0.0012 | 0.0001 | 0.0001 | 0 | 0.0009 | 0.0001 | 0.0014 | 0.0001 | 0.0005 | 0 | 0.0006 | 0.0001 | 0.0043 | 0.0001 | 0.0001 | 0.0002 | 0.0004 | 0.0001 |
| Nucleus | 0.002 | 0.0006 | 0.0005 | 0.0001 | 0.0015 | 0.0002 | 0.0132 | 0.0002 | 0.0006 | 0.0001 | 0.0018 | 0.0003 | 0.0017 | 0.0004 | 0.0004 | 0.0064 | 0.0015 | 0.0004 |
| Peroxisomes | 0.0179 | 0.0137 | 0.0117 | 0.0031 | 0.0109 | 0.0246 | 0.0535 | 0.0151 | 0.0255 | 0.0014 | 0.0243 | 0.0415 | 0.0181 | 0.014 | 0.0194 | 0.0099 | 0.0245 | 0.0106 |
| Punctate Nuclear | 0.0086 | 0.0008 | 0.0006 | 0.0002 | 0.0067 | 0.0004 | 0.0017 | 0.0006 | 0.0023 | 0.0003 | 0.0073 | 0.0007 | 0.0023 | 0.0004 | 0.0007 | 0.0024 | 0.0049 | 0.0009 |
| Vacuole | 0.004 | 0.005 | 0.0029 | 0.0029 | 0.0027 | 0.0018 | 0.0065 | 0.0021 | 0.0028 | 0.0021 | 0.0032 | 0.002 | 0.0027 | 0.0028 | 0.0031 | 0.0044 | 0.0041 | 0.0028 |
| Vacuole Periphery | 0.0018 | 0.0019 | 0.0018 | 0.0022 | 0.0028 | 0.0018 | 0.0017 | 0.0009 | 0.0019 | 0.0022 | 0.003 | 0.0015 | 0.0016 | 0.0015 | 0.0023 | 0.0025 | 0.005 | 0.0021 |
Sequencing Data
| R1 | R2 | |||||||||
|---|---|---|---|---|---|---|---|---|---|---|
| G1 Post-START | S/G2 | Metaphase | Anaphase | Telophase | G1 Post-START | S/G2 | Metaphase | Anaphase | Telophase | |
| Gene Expression | 90.4908 | 48.7099 | 47.7629 | 58.4821 | 61.8166 | 38.8992 | 76.5143 | 66.4816 | 53.9134 | 78.4236 |
| Translational Efficiency | 1.9373 | 3.158 | 2.115 | 1.456 | 1.9313 | 4.4396 | 1.7812 | 1.4781 | 1.6172 | 1.8059 |
Hit Data
| Dataset | Hit |
|---|---|
| Protein Concentration | ✘ |
| Protein Localization | ✔ |
| Gene Expression | ✘ |
| Translational Efficiency | ✘ |
Endocytosis
| Temp | Actin Patch (Sac6-tdTomato) | Cortical Patch (Sla1-GFP) | Late Endosome (Snf7-GFP) | Vacuole (Vph1-GFP) |
|---|---|---|---|---|
| 37℃ | ||||
| RT |
Cell Cycle Omics
CYCLoPs (Rer1-GFP)
| Gene / Allele | Actin Patch (Sac6-tdTomato) | Cortical Patch (Sla1-GFP) | Late Endosome (Snf7-GFP) | Vacuole (Sac6-tdTomato) |
|---|
| Gene | Images |
|---|
| Gene | Images |
|---|
Images are not yet available
Images are not yet available